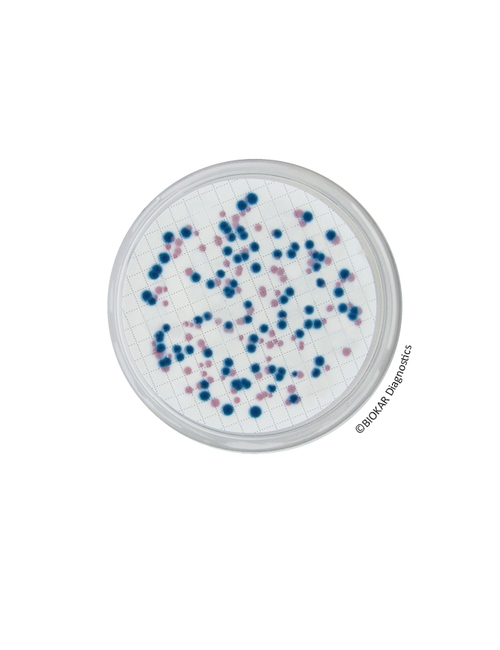
img

Chromogenic Coliform Agar (CCA)
COMPASS® CCA
Kromojenik (Chromogenic) Koliform Agar
Kromojenik Koliform Agar (Chromogenic Coliform Agar = CCA), içme suyu, dezenfekte havuz suyu veya arıtma tesislerinden bitmiş sular gibi düşük bakteri kirliliği olduğu düşünülen (100 toplam koloniden daha az bakteri içerdiği düşünülen) sularda Escherichia coli ve koliform bakterilerinin tespiti ve sayımı için kullanılır.
Ürün Adı: Chromogenic Coliform Agar (CCA)
Ürün Kodu: BM18208
Miktar: 20 Petri plates Ø 55 mm

Ürün Adı: Chromogenic Coliform Agar (CCA)
Ürün Kodu: BK204HA
Miktar: 500 g
